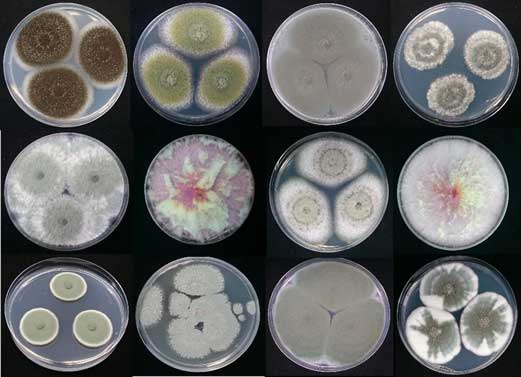

Prevención e mitigación da contaminación de alimentos e pensos por micotoxinas causada polo cambio climático (AGRITOX)
-
Acronimo:
AGRITOX
-
Programa:
Programa de cooperación Interreg Espazo Atlántico 2014-2020
-
Convocatoria:
2018 (segunda)
-
Fondos:
FEDER
-
Socios:
España: Universidade de Santiago de Compostela (socio principal), Laboratorio CIFGA, S. A., Deputación de Pontevedra-Estación Fitopatolóxica Areeiro
Portugal: Facultade de Ciencias da Universidade do Porto, Cooperativa Agrícola Vila do Conde
Irlanda: TEAGASC-Agriculture and Food Development Authority
Reino Unido: Queen's University Belfast
Francia: Agence Nationale de Sécurité Sanitaire de l'alimentation, de l'environnement et du travail
España: Agencia Española de Seguridad Alimentaria y Nutrición. Socio adxuntos
Portugal: Autoridade de Segurança Alimentar e Económica, Instituto Nacional de Investigação Agrária e Veterinária, I. P. Socio adxunto
-
Data de inicio:
01/04/2019
-
Data de fin:
30/06/2022
-
Orzamento elixible total:
1.954.138,80 €
-
Orzamento elixible Depo:
1.465.604,10 €
-
Subvención concedida total:
229.494,60 € €
-
Subvención concedida Depo:
172.120,95 €
AGRITOX é un proxecto de prevención e mitigación da contaminación de alimentos e pensos por toxinas naturais producidas por determinadas especies de fungos (micotoxinas). O principal obxectivo do proxecto é establecer unha cooperación internacional que contribúa a reducir os riscos e o impacto das micotoxinas na saúde, reforzar a seguridade na poboación e no medio e fortalecer a capacidade de recuperación e planificación das rexións da área atlántica para a xestión de riscos naturais e os derivados de actividades humanas.
AGRITOX contribuirá a mellorar os plans de acción de xestión de riscos e as estratexias da área atlántica para proporcionar unha resposta adecuada e coordinada a posibles riscos. O proxecto proporcionaralles ás industrias de alimentos e pensos do Espazo Atlántico información e solucións para evitar a contaminación por micotoxinas, un reto crecente debido ao cambio climático, e que representa un problema para a saúde.
Ligazóns de interese
